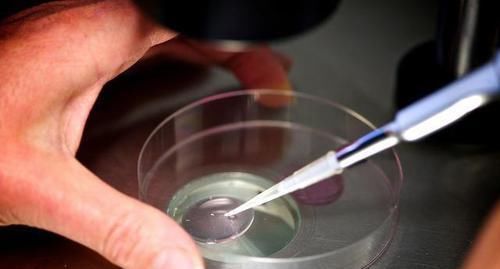
“试管婴儿”和正常孩子有什么区别不在于寿命长短,而是这一点

怀孕生子,莫过于是女性最幸福的时刻了。有一个自己的家庭,有一个夫妻俩共同的孩子,看着孩子一点点长大,这种幸福感不言而喻。但是对很多女性来说,怀孕的过程是困难的,各种身体问题或是生活压力导致越来越多的女性在自然怀孕的这条路上举步维艰。随着科技的发展,一项新的技术-试管婴儿技术对女性不孕不育问题起到了很大的帮助。给备孕未果的女性带来了生育的希望。

文章插图
玲玲和老公是对85后夫妻,两人结婚将近10年,夫妻感情一直不错,家里还养了一只可爱的金渐层猫咪,可是在双方父母和亲戚眼里,小两口的生活并不幸福,更不完美。只因两人一直没有小孩,说实话,两人都挺喜欢孩子的,为了怀上孩子,都没少跑医院,可惜肚子一直不见起色。婆婆曾偷偷问过儿子,是媳妇的问题吗?
看到儿子垂头丧气摇摇头,瞬间领悟到其中缘由,于是耳听八方打听各种备孕小秘方,最后还是劝小两口选择试管婴儿,年轻人当然都听过试管婴儿这回事,但是保守的玲玲一直担心试管婴儿不够聪明,身体发育不健康,于是乎一直处于观望状态。然而眼看着年龄往40岁挨近,最好还是决定选择做试管婴儿了。
那么试管婴儿技术到底是通过什么样的方式让胚胎成活呢,试管迎来的孩子和一般受孕的孩子又有什么样的区别呢?今天我们来揭开试管婴儿的面纱。

文章插图
所谓试管婴儿,就是在体外通过实验结合女性卵子和男性精子,形成胚胎。待胚胎成活之后再通过试管引入到女性的子宫,开始正常的孕育到分娩的过程。
虽然体外结合精子和卵子,增加了受孕成功的几率,但是这个过程也是非常的艰辛和痛苦。首先女性要先吃促排卵的药物,来促进身体多次排卵。取出的卵子不同于身体内一月排一次卵的规律,而是在药物的刺激下,会多排出十几个卵子,会很伤女性身体元气。医生会在这十几个卵子中选择最优质的卵子与精子结合,在这个阶段以及后期引入子宫的阶段,都要格外注意观察,稍有不慎,也会导致胎停。

文章插图
有人说试管婴儿的寿命不如自然孕育的胎儿长久,其实这是没有科学依据的,两者除去在孕育初期的方式有所不同,别的应该无他异样。真正可以算两者区别的,是在这一点上——遗传疾病的概率。
我们都知道,自然孕育的小生命,在遗传学概率上,会随机遗传到父母的显性和隐性基因,而这基因中有家族遗传病的概率。新生儿结合的过程,会遗传到基因中的好的和坏的部分,我们难以自然的分开,所以孩子出生难免会带有父母身上疾病的基因,后期发育中有遗传病发作的隐患。
文章插图
而试管婴儿在胚胎结合的初期阶段,就经过了人工的干预和筛选,从精子卵子中选择了最优质的进行结合,这样会让胚胎更加健康,生出的宝宝会很大程度避免携带遗传病基因,后期身体素质会相对更健康,减少生病。
【 “试管婴儿”和正常孩子有什么区别不在于寿命长短,而是这一点】总之,无论孕育的过程是怎样的,孕育的宝宝都是夫妻爱的结晶,只要宝宝能够有健康的身体,灵活聪明的大脑,家长就无需焦虑是自然孕育还是试管孕育。愿天下的女性都能孕育出健康的宝宝,成为幸福的宝妈。
- 宝妈|那个生完孩子没多久,就变成“老太太”的80后宝妈,后来咋样了
- 羊水|子宫黑漆漆,胎儿会无聊吗?这些“游戏”玩得可溜了
- 妈妈|喝“母乳”和喝“奶粉”的孩子,长大后有哪些区别3个区别明显
- 弓立芳|如何进行高质量亲子沟通?要“把话说进孩子心里”
- meg吃鱼的这些讲究,您知道吗?
- 父亲|“谁有吃的给我孩子吃一点”父亲在公交上求助,得知原因乘客泪奔
- 萌娃|“保镖奶爸”送娃上幼儿园火了,气场,步伐没谁了
- 宝妈|三个月的宝宝,为何“偏爱”竖抱?抱对了的宝宝更聪明
- 怀孕|3次胎停后...39岁的她能圆梦吗?
- 医生|让宝妈提心吊胆的“上环”,过程到底是怎么样的?可能会有点尴尬
